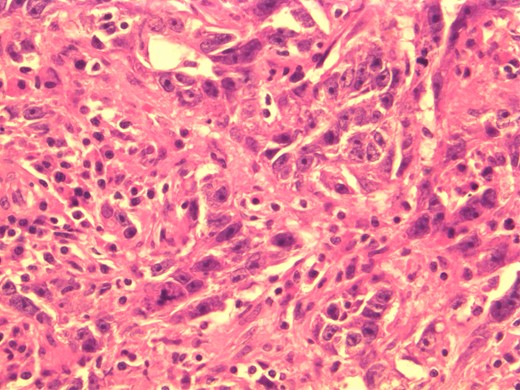
Photomicrograph: large nuclei with eosinophilic cytoplasm and prominent nucleoli consistent with apocrine differentiation.

-
PDF
- Split View
-
Views
-
Cite
Cite
Tyler Bedford, Adam Alperstein, Yashas Nathani, Robert Marx, Peter DeVito, A rare presentation of triple-negative apocrine breast carcinoma with metastases, Journal of Surgical Case Reports, Volume 2014, Issue 5, May 2014, rju045, https://doi.org/10.1093/jscr/rju045
Close - Share Icon Share
Abstract
Apocrine breast carcinoma is a rare subtype of the invasive ductal carcinoma and accounts for as little as 0.3–1% of all breast cancers. It is usually positive for human epidermal growth factor receptor 2 (HER-2) and negative for both estrogen receptor and progesterone receptor. Here we present an exceptionally rare case of apocrine breast carcinoma that is a triple receptor negative with metastases and to our knowledge this is the first published case. This is a significant finding because it implies that the tumor would not respond to the typical hormonal agents. This case highlights the need for studies to elucidate better treatment strategies for these types of patients.
INTRODUCTION
Apocrine breast carcinoma is a rare subtype of the invasive ductal carcinoma, characteristically composed of large cells, round nuclei, eosinophilic and granular cytoplasm, and has a predilection for females in the sixth and seventh decades [1]. Presentation varies from benign simple cysts to infiltrating lesions with metastases. Apocrine carcinoma is usually androgen receptor (AR) positive and commonly devoid of estrogen receptor (ER) and progesterone receptor (PR). It also frequently over expresses human epidermal growth factor receptor 2 (HER-2). Here we present a rare case of an elderly female with triple-negative apocrine breast cancer with metastases to the axillary lymph nodes and beyond.
CASE REPORT
A 72-year-old female with the history of hypertension and rheumatoid arthritis initially presented to the emergency department complaining of axillary pain and swelling for 2 months. The patient denied weight loss, fever, night sweats and weakness. She denied palpable breast masses and her previous mammogram from 2005 was BI-RADS 1.
Upon physical examination, multiple right axillary lymph nodes were markedly enlarged, measuring 2–3 cm. Gritty fullness to the right breast was noted with a questionable mass ∼2 cm from the areola at the 10 o'clock position. The remainder of the physical examination was benign.
A computed tomographic (CT) scan of her chest with contrast revealed moderate right axillary lymphadenopathy and a lesion in the upper outer quadrant of the right breast measuring 1.3 × 1.2 cm (Fig. 1). A positron emission tomography (PET) scan showed a small intense focus on the right lateral breast consistent with carcinoma, significant right axillary lymphadenopathy and intense fluorodeoxyglucose hypermetabolic activity consistent with metastatic spread. Additionally, enlarged lymph nodes extending along the upper chest wall just inferior to the subclavian vessels and posterior to the pectoralis muscles were seen. A needle biopsy of the mass revealed an extensive involvement of poorly differentiated infiltrating carcinoma (Fig. 2). The tumor showed large nuclei with eosinophilic cytoplasm and prominent nucleoli consistent with apocrine differentiation (Fig. 3). There was a significant inflammatory response to the infiltrating tumor noted. No lymphovascular invasion was identified within the core biopsies. The specimen was estrogen and PR negative as well as HER-2/neu negative.

Chest CT showing lesion in the right breast and moderate right axillary lymphadenopathy.

Photomicrograph: apocrine differentiation and inflammatory response.
Photomicrograph: large nuclei with eosinophilic cytoplasm and prominent nucleoli consistent with apocrine differentiation.
The findings were discussed with the patient and she subsequently underwent a modified radical mastectomy. Pathology of the specimens showed poorly differentiated apocrine carcinoma with extensive axillary node metastases (Fig. 4). The invasive carcinoma measured 1.5 × 1.4 × 1.3 cm without invasion into the skin or muscle. The margins were uninvolved.

DISCUSSION
Apocrine breast carcinoma is a rare subtype of invasive ductal carcinoma that accounts for as little as 0.3–1% of all breast cancers [2]. Apocrine breast carcinoma that is a triple receptor negative and with metastases is exceptionally rare entity and to our knowledge this is the first published case.
Presentation of apocrine breast carcinoma is not thoroughly defined but has been shown to be similar to its broader category of invasive ductal carcinomas. For instance, greater likelihood of disease is seen in women over 40, especially over 65. In general, hormonally dependent factors increase breast cancer risk, such as nulliparity or first child after 30, early menarche, late menopause and consuming more than three alcoholic beverages a day. Physical examination varies from asymptomatic to the presence of a hard anchored unilateral breast lump with irregular borders with or without skin or nipple retraction [3]. Clinically, there is little differentiation between invasive apocrine carcinoma and invasive ductal carcinoma. Both have a mean age of onset of 58.5 and 54.4 years, respectively. Both have an ∼12–15% recurrence rate, respectively. Death due to recurrent breast cancer is seen in ∼5–8% of cases. The difference in relapse-free survival and overall survival is almost identical; therefore, prognosis is similar between both these etiologies [4].
Workup is often made after suspicious findings on mammography are established which then prompts biopsy. This then allows for interpretation of histologic type, grade and size of the tumor to be classified, as well as edges and possible invasion to be identified.
Histologically, apocrine carcinomas display a characteristic granular eosinophilic cytoplasm, sharp boarders, round nuclei and prominent nucleoli [5]. Testing for expression of the GCDFP-15 protein on immunohistochemical staining has been used to diagnose apocrine breast carcinoma; however, decreased levels have been seen with advanced disease as well as node-positive apocrine carcinoma [6]. Detection of cancer spread can be made with chest X-ray, bone scan, CT, MRI and PET scan. After completion of these tests, one can determine the cancer's stage [7].
Biopsy is then tested for the presence of ER and PR via immunohistochemistry. Cancers with these receptors tend to respond positively to hormonal therapy, such as tamoxifen. The College of American Pathologists (CAP) and the American Society of Clinical Oncology proposed a guideline to also check for the presence of HER2 protein expression, as positivity tends to respond to therapies with trastuzumab or lapatinib [7]. The most remarkable finding with this case is that it is a triple-negative breast cancer (TNBC), implying that it does not express genes for ER, PR or HER-2/neu. This is a significant finding because it implies that the tumor won't respond as avidly to the typical hormonal agents [7].
In an attempt to better define apocrine carcinoma, much of the newest literature recommends the addition of androgen receptor expressivity on routine immunohistochemistry stains since these have been shown to test positive between 55 and 100% of the time [1]. This will also help differentiate apocrine carcinoma from other TNBCs since apocrine carcinoma clinically behaves differently from the usual basal-like TNBCs [8]. The finding of androgen receptor sensitivity with apocrine carcinomas may facilitate receptor-targeted therapy [9].
Although rare, it is important to distinguish apocrine breast carcinomas from other subtypes of invasive ductal carcinomas since they may not respond to the typical hormonal agents. The diagnosis and treatment of apocrine carcinoma is a challenge. To our knowledge this is the first reported case of a triple-negative apocrine breast carcinoma that has metastasized. This case helps highlight the need for a more formal treatment strategy for patients with apocrine breast carcinoma. Further studies are needed to elucidate better treatment strategies for these types of patients.